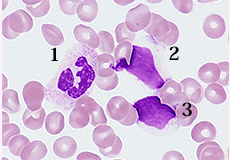

第37回 「マンスリー形態マガジン」 2014年5月号
『 新任さんに少しのアドバイス 』
前 略
今年も全国の検査室に多くの新任の臨床検査技師が誕生したことと思います。
第60回臨床検査技師国家試験(2014.2.19実施)の合格者は、全体では81.2%、新卒者は94.3%だそうで例年になく好成績を収めているようです。大きな夢と希望を持って仕事に挑んでいることと思われますが、緊急検査などの対応から他部署の業務を覚えることに悪戦苦闘していることかも知れませんね。
1968年、私は名古屋保健衛生技術短期大学1期生(現藤田保健衛生大学)を卒業し、衛生検査技師として世に羽ばたいたものの、わずか2年の学生教育と世間には馴染みのない職も重なり、職場でおどおどしながら業務に取り組んでいたものでした。しかし現在は、しっかりとしたカリキュラムのもとハイレベルな学生教育が行き届くなか胸を張っての門出を迎えた諸氏が多いことでしょう。
私の社会人のスタートは民間病院でした。臨床検査技師を多く抱える施設では先輩の指導を仰ぐことに時間はかかりませんが、民間病院ではそうはいきません。少数精鋭とは申しますが、その実現にはほど遠く、地域の研修会などに積極的に参加して他施設の先輩技師を知りそして指導を仰いだことが思い出されます。
民間で7年過ごした後、運もあり国立病院に採用され6回ほどの異動はありましたが、節目の折に良き先輩諸氏に恵まれた事が今日の大きな支えとなっております。少数規模の国立病院に異動する際、ある先輩技師が “阿南くん、大きな施設で頑張るのは当たり前、小さな施設で如何に頑張れるかだよ”、そのお言葉、退職した今でも肝に銘じて生きています。
今の私に言えることは、業務に対して協調性をもちながら“真実(まこと)の汗”をかくことであり、“自分を守るのは自分しかいない”という強い信念と自尊心をもって取り組むことが肝要であると信じております。
草々
形態マガジン号キャプテン 阿南 建一 

我が家のハナミズキです!
(2014.4)
花言葉には、「私の思いを受けて下さい」
「公平にする」「返礼」「華やかな恋」と
色々ありますが、私の形態学への思いが
伝わります様に・・・
今回のねらい
あちらこちらで新任の血液担当技師さんが顕微鏡とにらめっこしている様子が窺えそうです。学生教育とは異なった実践の日々に戸惑いを抱えながら日々検査に励んでいることでしょう。あこがれの先輩技師さんのご指導を仰いで成果をあげるように頑張ってください。
本マンスリーマガジンはそのような方を対象としたデータベースですので今年度も細胞形態の基本から取り組んでいきますので、一人でも多くの“血液形態すきすきグループ”が増えることを祈りながら1年間お付き合いください。しばらくは末梢血液像の細胞同定に挑みます。
問題
CASE A~Dにおける末梢血液像の細胞同定をリストより選択してください。
-
PM-MG ×1000

-
PM-MG ×1000

-
PM-MG ×1000

-
PM-MG ×1000

末梢血液に図のような芽球が多くみられました。そのペルオキシダーゼ染色ですが設問に答えてください。
-
PM-MG ×1000

解答・解説
- ( PB-MG ×1000 )

( PB-MG ×1000 )

( PB-MG ×1000 )

( PB-MG ×1000 )

- (正解と解説)
【正解】
(CASE A) 1-②.分葉核球, 2-⑤.リンパ球, 3-⑤.リンパ球
【解説】
(CASE B) 1-⑤.リンパ球, 2-⑤.リンパ球
(CASE C) 1-②.分葉核球, 2-②.分葉核球, 3-①.桿状核球
(CASE D) 1-⑧.単球, 2-④.好塩基球
(CASE A)
1.核のくびれ(7時方向)とクロマチンの結節が強いことより分葉核球に同定しました。
2.N/C比は低く、核は類円形で、クロマチン網工は粗鋼で平坦状、細胞質は淡青色で、アズール顆粒が散見されることよりリンパ球(顆粒リンパ球)に同定しました。
3.2.と同様でリンパ球に同定しました。
(CASE B)
1.上述したものと同様にリンパ球(顆粒リンパ球)に同定しました。 2.大きさは16μmを超えることで異型リンパ球に同定したいところです。異型リンパ球とは抗原刺激を受けたリンパ球であり、16μm以上の大きさと細胞質の好塩基性が特徴のようです。
本細胞は細胞質の淡青色はリンパ球の様相であることより大リンパ球に同定しました。
(CASE C)
桿状核球と分葉核球は好中性顆粒球における成熟の最終段階ですが、核の形状、クロマチンの結節の程度は大きく変わります。
1.核のくびれ(分葉)とクロマチンの結節が強いことより分葉核球に同定しました。 2.核の分葉とクロマチンの結節が強いことより分葉核球に同定しました。 3.核は湾入がみられバナナ状、ブーメラン状を呈し、核にくびれがみられないことやクロマチンの結節がさほど強くないことより桿状核球に同定しました。
(CASE D)
1.単球は大リンパ球(12~16μm)に比べ大型(13~21μm)で、核形不整がみられクロマチン網工は繊細で、細胞質に微細なアズール顆粒が充満してみえます。 2.14μm大の好塩基球で、紫赤色の粗大顆粒は水溶性の性質から染色の工程で抜けることが多く、残存する顆粒は核の上にも散見されることが特徴です。
- ( PB-MG ×1000 )

- (正解と解説)
【正解】
[設問1] ④.骨髄芽球が染まっている
[説問2] ④.急性骨髄性白血病を疑う
【解説】
末梢血に出現した2個の芽球を提示しました。
大型でN/C比が低く、核形不整はなく、クロマチン(核網)工は繊細で核小体を認めます。
11時方向の芽球はPO染色に弱陽性がみられますので骨髄芽球が推測されます。
単芽球にも類似していますが、クロマチン網工が繊細であることやPO染色に陽性のことが合致しません。本例は急性骨髄性白血病(AML-M1)の症例です。
これから先のページでは、医療関係者の方々を対象に医療機器・体外診断薬等の製品に関する情報を提供しております。当社製品を適正に使用していただくことを目的としており、一部の情報では専門的な用語を使用しております。
一般の方への情報提供を目的としたものではありませんので、ご了承ください。
医療関係者の方は、次のページへお進みください。
(お手数ですが、「進む」ボタンのクリックをお願いします)
